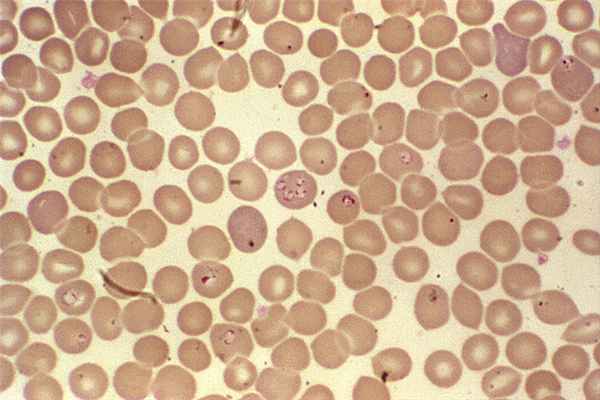
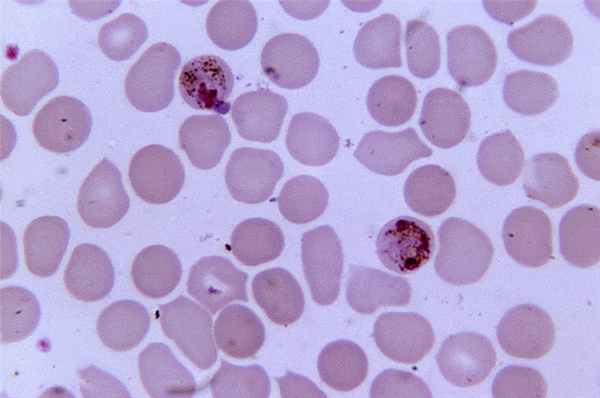

Паразитизм в эпидемиологии. Паразитические микроорганизмы.
Добавил пользователь Cypher Обновлено: 02.11.2025
Клиническая картина характеризуется воспалением желчных ходов, что приводит к патологическим изменениям и различным аллергическим реакциям. При отсутствии лечения паразитирование резко повышает риск развития онкологии и иммуноопосредованных состояний.
Причины
Описторхоз вызывают паразитические черви нематоды рода Opisthorchis ― печеночные сосальщики. Всего в природе насчитывают свыше 30 видов. В России, Украине, Казахстане встречается Opisthorchis felineus, который также имеют кошачьей или сибирской двуусткой. Наиболее высокий риск заражения в районах рек: Бирюса, Волга, Днепр, Дон, Иртыш, Кама, Обь, Северная Двина, Урал.
Длина тела паразита варьируется от 8 до 18 мм, ширина ― от 1 до 2 мм. Первыми промежуточными хозяевами становятся пресноводные рыбы и брюхоногие моллюски (речные и озерные улитки). Они заглатывают яйца описторхиса вмести с илом и фекалиями конечных хозяев. В их телах они живут около 2 месяцев, преобразуясь в церкарий ― свободно плавающих личинок. В этом виде они могут самостоятельно внедряться в тело рыбы.
Паразит присасывается к волокнам мышц, где превращается в метацеркарий ― округлую цисту размером от 0,16 до 0,20 мм. Спустя 6 недель после заражения рыбы, метацеркарий становится инвазионным, т. е. готовым перейти в конечного хозяина. В это время личинки внутри цист очень подвижны. Имеют 2 присоски.
Конечный хозяин описторхис ― человек и млекопитающие, чаще медведи, представители семейства псовых и кошачьих. Заражение происходит путем поедания рыбы с цистами. Чаще всего зараженной бывает язь, лещ, плотва, пескарь, красноперка, гольян.
В конечном хозяине паразит освобождается от цисты в желудке и тонком кишечнике. Из органов ЖКТ он передвигается в желчный пузырь, протоки, печень, где и достигает половозрелости. Спустя пару недель описторхисы начинают откладывать яйца. Срок жизни паразита может доходить до 20 лет. Взрослых особи в 100% случаев паразитируют в печеночных желчных протоках, в 60% случаев их можно обнаружить в желчном пузыре, в 40% ― в протоках поджелудочной железы. Они питаются кровью и окружающей тканью.
Симптомы
Чаще клиническая картина смазана, имеет слабо выраженную симптоматику. Первые признаки заражения проявляются когда наступает хроническая стадия. В последние десятилетия острое течение болезни наблюдается только у людей, проживающий в районах с благоприятной эпидемиологической обстановку по описторхозу.
Патогенез выражается в механическом и токсическом воздействий паразитов на организм. Наибольший ущерб терпят стенки желчных ходов, когда описторхисы передвигаются по места окончательной дислакации. При фиксации к слизистым при помощи присосок они также наносят значительный ущерб: нарушают кровообращение и отток желчи и секреции поджелудочной железы. Из-за них деформируются окружающие ткани, возникают кистознообразные расширения желчных ходов.
Из-за патологических изменений, нанесенных паразитом, увеличивается риск развития других инфекций. Более активно начинают размножаться бактерии. У некоторых пациентов развиваются гнойные холангиты ― хронические воспаления желчных протоков.
Описторхисы выделяют продукты обмена в организм хозяина. Это приводит к периодическим вспышкам аллергии. Выражается это кожным дерматитом, чаще всего проявляющимся на лице. Эти паразиты внесены в список МАИР, как канцерогены первой категории.
Симптомы острого описторхоза
- Повышение температуры тела от 37,1 до 38,0°C, продолжающейся до 4 недель.
- Аллергическая реакция, высыпания на лице в зоне «Т», иногда на теле. Длительность проявлений около 2 недель.
- Частые головные боли, миалгии и артралгии.
- Слабость, нарушение сна, снижение аппетита и работоспособности.
- Повышенное потоотделение.
Достаточно часто возникает бронхолегочный синдром. Начинается с першения в горле, сопровождается сухим кашлем и одышкой. На фоне нарушений здоровья могут развиться вторичные воспалительные процессы в верхних дыхательных путях. Признаки схожи с сезонным ОРЗ, поэтому часто воспринимаются за простуду.
Симптоматика со стороны ЖКТ выражается в чувстве тяжести, вздутии и болевом синдроме в правом подреберье. Печень увеличивает свои размеры, болезненна при пальпации. После еды возникает изжога, горечь во рту. Может быть рвота.
В некоторых случаях, особенно у пациентов, имеющих заболевание печени, развивается желтуха. В этом случае к желтушности кожных покровов и склер добавляется зуд кожи, моча темнеет, кал становится светлым. Спустя несколько недель организм приспосабливается к текущим условиям и симптоматика отступает. Заболевание переходит в хроническую стадию.
Симптомы хронического описторхоза
В последнее время часто отмечается латентное течение описторхоза. Симптоматика может отсутствовать годами. В остальных случаях картина настолько смазана, что представляет собой «сборник разнообразных симптомов». При этом они вообще никак не связаны между собой, что ставит в тупик молодых неопытных врачей. Однако, пациентам, проживающим в неблагоприятной эпидемиологической обстановке испытывать проблем с диагностированием не приходится.
Наиболее часто встречающиеся жалобы:
- Дискомфорт и слабый болевой синдром в правом подреберье.
- Кишечные расстройства (тошнота, изжога, метеоризм, неустойчивый стул, сменяющийся то поносом, то запором).
- Увеличение печени, боль при пальпации, в том числе в районе проекции желчного пузыря.
Сила симптомов может нарастать после принятия пищи. К общим признакам относятся повышенная утомляемость и потливость. Становится труднее работать в прежнем режиме. Ощущается упадок физических сил и умственных возможностей. Периодически может возникать кратковременное повышение температуры тела. Появляется отвращение к тяжелой, жирной и острой пище.
Если у пациента присутствуют какие-либо хронические заболевания, они обостряются. Сложнее добиться положительного результата, лечение перестает быть таким же эффективным, как ранее. Как и при острой стадии, периодически возникают аллергические реакции в виде сыпи и зуда.
Классификация и стадии
По степени тяжести течения описторхоз делят на:
- легкую форму;
- среднетяжелую;
- тяжелую форму.
По характеру клинических признаков острый описторхоз разделяют на следующие виды:
- Инаппарантная форма — характеризуется слабо выраженной симптоматикой. Как правило, наблюдается у коренных жителей эндемичных районов. Это обусловлено врожденной иммунной толерантностью, организм легко приспосабливается к наличию паразитов, не воспринимая их как чужеродный объект.
- Манифестная ― ярко выраженная клиническая форма. Сопровождается обширной симптоматикой: общей, со стороны ЭКТ, аллергической. Наблюдается у населения не имеющего врожденной устойчивости к данному виду паразитов.
- Тифоподобная форма. Встречается редко, выражается в микробной активности на фоне ослабленного иммунитета.
- Гепатохолангитическая форма. Основные симптомы инвазии ― воспаления печеночных желчных ходов. Выражается в слабости, коликах в правом подреберье, симптомами желтухи.
- Гастроэтероколитическая форма выражается в затруднении переваривания пищи. Среди симптомов: боли и дискомфорт в эпигастральной области, ощущение наполненного желудка в начале приема пищи, чувство распирания, вздутия живота, тошнота.
- Смешанная форма, при которой сложно выделить основное расстройство. Как правило, это обусловлено наличием паразитов в желчном пузыре, протоках печени и поджелудочной железы одновременно.
Хронический описторхоз также делят на:
- латентный (бессимптомный);
- манифестный вид с преобладанием гепатитной клинической картины, холецистохолангитической, гастроэнтеритической, панкреатической или смешанной симптоматики.
После проведения терапии, остаются резидуальные проявления перенесенной болезни. В дальнейшем они квалифицируются как самостоятельное заболевание. К нам относятся гастрит (воспалительно-дистрофические изменения желудка), дуоденит (воспаление 12-перстной кишки), холангит (воспаление желчных протоков), холецистит (воспаление желчного пузыря), панкреатит (воспаление поджелудочной железы) и цирроз печени.
Диагностика
Из-за богатства клинических проявлений важным является проведение лабораторных анализов. Важно учитывать проживание пациента в эндемичном районе, принадлежность к коренным народам Севера и недавнее употребление в пищу недостаточно обеззараженной рыбы.
Лабораторная диагностика
- Клинический анализ крови — главный анализ в диагностировании описторхоза. Информативность около 90%. При наличии паразитической инвазии отмечается высокая эозинофилия в остром периоде течения болезни, доходящая до 60х109/л. В хронической стадии повышение числа эозинофилов умеренное, со временем приходит в норму. в некоторых случаях наблюдается пониженный уровень гемоглобина и тромбоцитов, при этом скорость оседания эритроцитов повышена.
- Биохимический анализ крови. В острой фазе определяют повышение:
- уровней АЛТ и АСТ;
- уровней гамма-глютамилтранспептидаз и амилазы;
- щелочной фосфатазы;
- общего билирубина.
Иногда наблюдается умеренное повышение этих показателей и в хронической стадии.
Иммуноферментный анализ крови позволяет определить наличие антител к антигенам описторхис. анализ имеет высокий процент информативности в период острого течения болезни. В хронической стадии вероятны ложноположительные результаты при наличие аутоиммунных патологий и других видов гельминтов. Поэтому исследование проводят совместно с клиническим и биохимическим анализами.
Дуоденальное зондирование — введение веществ стимулирующих выход желчи. Ее захватывают через зонд для дальнейшего изучения. При описторхозе в желчи обнаруживают яйца, повышенное содержание лейкоцитов, мертвые и неразложенный частицы паразитов, клетки эпителия. Это исследование на данный момент наиболее результативное. Информативность достигает 99%.
Копроовоскопия — исследование кала на наличие яиц описторхисов. Информативен в первые 6 месяцев с момента инфицирования. Для повышения результативности рекомендуем проводит исследование 3-кратно. При этом, на вредя диагностики следует исключить растительную клетчатку. Временно стоит отказаться от употребления овощей, фруктов, каш и хлебобулочных изделий.
Инструментальная диагностика
При тяжелом и среднетяжелом течении болезни проводят:
- Дуоденальное зондирование для определении типа нарушения желчевыводящих путей.
- УЗИ органов брюшины для диагностирования поражения желчных протоков печени.
- Фиброгастродуоденоскопия для исследования состояния слизистой оболочки двенадцатиперстной кишки и других органов системы ЖКТ.
Может быть назначено рентгенологическое исследование, компьютерная томография или магнитно–резонансная томография органов брюшной полости.
Дифференциальная диагностика
Для постановки диагноза «описторхоз» необходимо выявить у больного эпидемиологический анамнез, яйца паразитов и соответствующие болезни лабораторные признаки. Также следует исключить:
- другие паразитарные инфекции;
- гепатиты вирусной и бактериальной этиологии;
- лептоспироз;
- иные кишечные инфекции, заболевания печени и поджелудочной железы.
В последние годы отмечается снижение интенсивности инвазии по непонятным пока причинам. Это может быть как действительное снижение числа больных, так и, наоборот, увеличение распространения описторхоза. Известно, что при высокой интенсивности инвазии у этого вида паразитов останавливается половое развитие вплоть до атрофии половых органов. Таким образом описторхизы регулируют свою численность, сокращая общее выделение яиц в зоне своего территориального обитания.
Лечение
Из-за высокое риска развития тяжелых токсико-аллергических реакций, терапию описторхоза в острой форме проводят в стационаре под наблюдением врача-инфекциониста. Лечение предусматривает решение нескольких задач:
- купирование развития патологий;
- предупреждение осложнений;
- уменьшение вероятности перехода в хроническую форму.
При выборе тактики проведения терапии учитывают клинические проявления, возраст пациента, наличие осложнений. Назначается № 4 или № 5 диета по Певзнеру, обильное питье, соблюдение режима.
Медикаментозное лечение включает препараты этиотропной и патогенетической терапии. Проводятся дезинтоксикационные и антигистаминные мероприятия.
Затем приступают непосредственно к терапии описторхоза, используя для лечения антигельминтик. Препарат эффективен против большинства нематод и цист, поскольку обладает хорошей проницаемостью клеточных мембран. Противопоказанием является беременность и острая фаза сопутствующих заболеваний. С осторожностью лекарство назначают пожилым людям и лицам с тяжелой патологией сердца, почек, печени.
Лечение хронического описторхоза
Терапия хронической формы заболевания может проводится амбулаторно и в стационаре в зависимости от состояния здоровья пациента и тяжести клиники. Принцип лечения аналогичен мероприятиям проводимым при острой форме с той разницей, что подготовительных мероприятий, как правило, не требуется. Организм адаптирован к наличию паразитов.
При проведении антигельминтной терапии необходимо наблюдать за состоянием здоровья. Массовая гибель паразитов приводит к усилению аллергических проявлений. Это состояние необходимо нормализовать антигистаминными препаратами. Также необходимы препараты для восполнение электролитных нарушений и восстановления водно-электролитного баланса.
Важно нормализовать функции печени, моторики моторику ЖКТ и гепатобилиарной области, восстановить микробиоту кишечника и уменьшить воспаление. Эффективность лечения описторхоза контролируется лабораторными показателями. После достижения положительного результата, пациенту показана реабилитационная терапия. Устанавливается диспансерное наблюдение. В течение 1 года после выздоровления периодически проводят лабораторные анализы и осмотры у инфекциониста и гастроэнтеролога.
Реабилитационные мероприятия начинают проводит практически с одновременно с началом лечения. Комплексный характер принимаемых мер с участием различных специалистов помогает максимально вернуть утраченное здоровье. Рекомендовано санаторно-курортное лечение.
Выздоровление
Критерием выздоровления служат:
- Отрицательные результаты исследования желчи.
- Снижение титров антител.
- Отрицательные результаты копроовоскопии, проведенной трехкратно.
При этом, паразитологическое выздоровление не всегда приводит к клиническому выздоровлению. Если пациент страдал описторхозом на протяжении 5 лет и больше, то, как правило, симптоматика периода хронической фазы сохраняется. Это обусловлено глубокими морфологические изменениями в тканях и слизистых поврежденных органов.
Осложнения
Описторхизы чрезвычайно прожорливые паразиты. В процессе своей жизнедеятельности они наносят значительный урон тканям печени, структуре желчных протоков, желчному пузырю и поджелудочной железе. Питаются черви не только слизью протоков, но и самой слизистой. Ротовой присоской они отрывают и поедают клетки тканей и выступающую кровь. В результате остаются кровоточащие ранки, которые впоследствии зарастают рубцами, неспособными выполнять функцию органа.
Из-за значительного ослабления иммунной системы присоединяются вирусные и бактериальные инфекции. Значительные объемы перерожденной рубцовой ткани могут привести к развитию злокачественных опухолей. Большое количество паразитов способно закупорить желчные протоки, деформировать их, нарушить отток желчи. Среди наиболее часто встречающихся заболеваний, появившихся на фоне описторхоза ― абсцессы печени, перитонит, миокардит, канцерогенез.
Абсцесс печени
Патология развивается вследствие хронического воспаления печени. Органические скопления гноя могут быть одиночными и множественными. Наиболее крупные гнойники требуют вскрытия, чрескожного наружного дренирования. Отсутствие лечения может привести к перфорации с соседние области.
Абсцесс сопровождается гектической лихорадкой ― быстрый подъем температуры до +40С и последующий спад в течении дня. Среди других симптомов боль с правой стороны брюшины и нейтрофильный лейкоцитоз (аномально высокое количество нейтрофилов в крови). пациент чувствует общее недомогание, повышенную утомляемость, снижение аппетита.
Желчный перитонит
Состояние характеризуется клиникой острого живота:
- острый болевой синдром в правой стороне брюшины;
- патологическое напряжение мышц брюшной стенки.
К этому приводят деструктивные поражения органов гепатобилиарной системы, сопровождающиеся излитием желчи в брюшину. Следует напомнить, что при симптоматике острого живота требуется немедленная госпитализация. Больному запрещено пить, есть, принимать обезболивающие.
Длительное пребывание в этом состояние приведет к проникновению желчных кислот в кровь, формированию сепсиса, инфекционно-токсическому шоку и гипогликемической коме.
Острый миокардит
На фоне описторхоза из-за токсико-аллергической реакции организма может развиться острый миокардит. Для этого состояния характерны тяжесть и болевые ощущения в области сердца. Нарушением сердечного ритма ― номотопные аритмии возникают в ночные часы. Их вызывают продуктов метаболизма описторхисов, которые негативно воздействуют на синусно-предсердный узел и рецепторы.
В результате длительных инвазий развивается выраженная тканевая эозинофилия сердечных стенок. Лейкоцитарной агрессии подвергаются контаминированные кардиомиоциты. Со временем это приводит к патологии сердечной мышцы ― кардиосклерозу.
Канцерогенез
Одно из тяжелых осложнений описторхоза: рак поджелудочной железы и рак желчевыводящей системы. Заболевание проявляется длительными тупыми болями, желтушностью, длительно держащейся температурой от +37 C до +38 C, снижением аппетита, похудением, вздутием живота. Другие симптомы зависят от наиболее пострадавшего органа.
Для рака поджелудочной железы характерно бессимптомное развитие. Как правило, опухоль обнаруживают лишь на 3 - 4 стадии. Поэтому важно пройти полное обследование при диагностировании описторхоза.
Рак желчевыводящей системы ― это опухоли внутри желчного пузыря и внепеченочных протоков. Могут встречаться одиночные и множественные новообразования. Болезнь имеет неблагоприятных прогноз. Средняя продолжительность жизни с момента постановки диагноза ― 1 год.
Прогноз и профилактика
Описторхоз можно назвать заболеванием, которые легче предотвратить, чем бороться в его последствиями. Для этого достаточно не употреблять недостаточно обработанную рыбу и мясо диких животных. Следует избегать употребления строганины, малосольной рыбы. Уничтожить паразитов можно не только термической обработкой, но и холодом. Достаточно заморозить продукт при температуре -28 С в течении 32 часов.
Паразитизм в эпидемиологии. Паразитические микроорганизмы.
Паразитизм в эпидемиологии. Паразитические микроорганизмы.
Нельзя также не учитывать, что основные успехи в лечении инфекционных болезней стали возможны в связи с открытием антибактериальных средств, а также иммунотерапии, т.е. в связи со специфической этиотропной терапией.
Наконец, успехи в профилактике и борьбе с многими инфекционными болезнями были достигнуты почти исключительно на основе знания этиологических факторов и разработки специфических средств и методов борьбы с ними. Наглядным примером в этом отношении является специфическая иммунопрофилактика инфекций, с помощью которой удалось ликвидировать натуральную оспу, резко снизить заболеваемость полиомиелитом, корью, дифтерией, коклюшем, столбняком и др.
Возбудителям инфекционных болезней, как и всяким живым существам, присущи самовоспроизведение, изменчивость, саморегуляция, размножение, раздражимость, реактивность и другие биологические свойства. Не менее существенным их свойством является феномен паразитизма, главным образом определяющий сущность всякого инфекционного процесса.
В наиболее общем виде понятие «паразитизм» подразумевает форму взаимоотношений между двумя организмами разных видов, при которой один (паразит) использует другого (хозяина) в качестве источника питания и (или) среды обитания, причем оба организма находятся между собой в антагонистических отношениях.
Неотъемлемым критерием паразитизма являются патогенное воздействие паразита на хозяина и ответная защитная реакция со стороны хозяина.
Следует указать, что в самом термине «патогенность» (греч. pa thos - страдание, болезнь + gennao - создавать, производить; син. болезнетворность) не заложено указание на его приложимость только к микроорганизмам. Следовательно, его можно относить к любому фактору, способному вызывать болезнь (например, к химическому веществу, механическому воздействию и т.п.), и можно утверждать, что всякий паразит является патогенным фактором, но не всякий патогенный фактор является паразитом.

Когда речь идет о паторенности микрорганизмов, то подразумевается постоянный видовой генотипический признак, характеризующий потенциальную способность микроорганизмов приживаться в тканях организма хозяина и размножаться в них, вызывая патологические изменения, т. е. инфекционный процесс. Таким образом, патогенность микроорганизмов отличается от патогенности факторов любой другой природы своей биологической сущностью, свойственной живому.
Паразитические микроорганизмы обладают некоторыми факторами патогенности, которые по функциональному значению подразделяются на следующие группы:
- инвазивные, т. е. способствующие внедрению в ткани макроорганизма (ворсинки бактерий, способствующие проявлению адгезивных свойств, т. е. прилипанию бактерий к эпителиальным клеткам слизистых оболочек, и ферменты - гиалуронидаза, нейраминидазы, муциназы и др.);
- придающие устойчивость к защитным факторам организма (капсульные полисахариды и полипептиды; липополисахариды и протеиды клеточной стенки и др.);
- токсические (экзо- и эндотоксины), проявляющиеся в некротизирующем действии на ткани хозяина в месте локализации паразита и обусловливающие специфику общих клинических проявлений болезни.
Оболочечные антигены, расположенные на поверхности микробной клетки, являются основными носителями свойств, определяющих специфичность микроорганизмов: с ними связаны образование и накопление специфических антител в инфицированном организме и др.
Специфическим свойством патогенных микроорганизмов является их органотропность (или тканевый тропизм), представляющая собой приспособленность их к обитанию в среде определенных органов и тканей, выработавшуюся в процессе эволюционного развития. Попадание патогенного микроба в организме не в ту среду, к которой он адаптирован, не сопровождается развитием типично протекающего инфекционного процесса.
Таким образом, можно утверждать, что качественное своеобразие всего класса инфекционных болезней определяется в первую очередь спецификой их причинного фактора, т. е. спецификой живого возбудителя.
В клиническом плане наиболее характерными специфическими особенностями этого класса болезней, принципиально отличающими его от неинфекционных, являются:
- характерное для массы инфекционных болезней циклическое течение заболевания, т. е. определенная последовательность развития, нарастания и убывания симптомов;
- возможность течения инфекционного процесса без клинически выраженных проявлений, в виде бессимптомного («здорового») носи-тельства;
- зачастую возникающая более или менее продолжительная невосприимчивость к повторному заболеванию, вызываемому тем же видом и типом возбудителя, после перенесенного заболевания в результате иммунной перестройки;
- развитие в результате некоторых инфекций повышенной чувствительности к возбудителю, определяющей возможность рецидивов и реинфекций.
Информация на сайте подлежит консультации лечащим врачом и не заменяет очной консультации с ним.
См. подробнее в пользовательском соглашении.
Трансмиссивные болезни
Переносчики — это живые организмы, способные передавать патогенные микроорганизмы от человека к человеку или от животных людям. Многие из этих переносчиков являются кровососущими насекомыми, в организм которых попадают болезнетворные микроорганизмы во время питания кровью зараженного хозяина (человека или животного) и которые затем, после репликации патогена, переносят эти микроорганизмы новому хозяину. Зачастую после однократного попадания патогена в организм переносчик становится заразным на протяжении всего жизненного цикла и передает болезнетворные микроорганизмы при каждом укусе/во время каждого акта питания.
Трансмиссивные болезни
Трансмиссивные болезни — это заболевания человека, возбудителями которых являются паразиты, вирусы и бактерии, и передаваемые переносчиками. Ежегодно во всем мире более 700 000 человек заболевают такими болезнями как малярия, лихорадка денге, шистосомоз, африканский трипаносомоз человека, лейшманиоз, болезнь Шагаса, желтая лихорадка, японский энцефалит и онхоцеркоз.
В тропических и субтропических районах бремя этих болезней особенно велико, и от них особенно сильно страдает беднейшее население. С 2014 г. в ряде стран мира многие люди пострадали или погибли в связи с крупными вспышками денге, малярии, чикунгуньи, желтой лихорадки и болезни, вызванной вирусом Зика, а системы здравоохранения испытали колоссальную нагрузку. Другие заболевания, такие как чикунгунья, лейшманиоз и лимфатический филяриоз, оставляют после себя стойкие последствия, обрекают людей на страдания на протяжении всей жизни, приводят к инвалидности и, порой, к стигматизации.
Перечень трансмиссивных болезней, в разбивке по переносчику
Ниже представлен неполный перечень трансмиссивных болезней, который упорядочен по переносчику. Кроме того, в перечне указан тип патогенного микроорганизма, вызывающего болезнь у человека.
Переносчик
Вызываемое заболевание
Тип патогенного микроорганизма
Комары
Лихорадка долины Рифт
Лихорадка Западного Нила
Водные брюхоногие моллюски
Мошки
Онхоцеркоз (речная слепота)
Блохи
Чума (передается от крыс людям)
Вши
Эпидемический возвратный тиф, переносимый вшами
Москиты
Москитная лихорадка (флеботомная лихорадка)
Клещи
Геморрагическая лихорадка Крым-Конго
Возвратный тиф (вызывается боррелиями)
Риккетсиальные заболевания (сыпной тиф и квинслендская лихорадка)
Триатомовые клопы
Болезнь Шагаса (американский трипаносомоз)
Мухи це-це
Сонная болезнь (африканский трипаносомоз)
Деятельность ВОЗ
В 2017 г. Всемирной ассамблеей здравоохранения был одобрен документ «Глобальные меры по борьбе с переносчиками инфекции (ГМПБИ) на 2017–2030 гг.». Документ содержит руководящие указания стратегического характера для стран и партнеров по развитию, позволяющие в кратчайшие сроки повысить эффективность борьбы с переносчиками инфекции, признанной основным методом профилактики болезней и реагирования на вспышки. Для достижения этой цели необходимо повышение согласованности программ по борьбе с переносчиками, повышение технического потенциала, совершенствование инфраструктуры, укрепление систем мониторинга и эпидемиологического надзора, а также более активное участие местных сообществ. В конечном счете все это будет способствовать осуществлению комплексного подхода к борьбе с переносчиками болезней, что создаст условия для достижения национальных и глобальных целей по борьбе с отдельными заболеваниями и будет содействовать достижению Целей в области устойчивого развития и обеспечению всеобщего охвата услугами здравоохранения.
Секретариат ВОЗ предоставляет стратегические, нормативные и технические рекомендации странам и партнерам по развитию, касающиеся усиления борьбы с переносчиками болезней как фундаментальной, основанной на ГМПБИ стратегии профилактики болезней и реагирования на вспышки. В частности, в связи с проблемой трансмиссивных болезней ВОЗ принимает следующие меры:
- предоставление основанных на доказательных данных рекомендаций по борьбе с переносчиками и защите людей от заражения;
- оказание технической поддержки странам с целью обеспечить возможность эффективного ведения случаев заболеваний и реагирования на вспышки;
- оказание странам поддержки в совершенствовании системы регистрации случаев и определении точных характеристик бремени болезни;
- помощь в проведении профессиональной подготовки (укрепление потенциала) по вопросам клинического ведения пациентов, диагностики и борьбы с переносчиками совместно с некоторыми сотрудничающими центрами; и
- содействие в разработке и оценке новых методов, технологий и подходов, касающихся трансмиссивных заболеваний, включая технологии и средства борьбы с переносчиками и ведения трансмиссивных заболеваний.
Первоочередное значение в деле снижения бремени трансмиссивных болезней имеют поведенческие изменения. ВОЗ сотрудничает с партнерскими организациями по линии просветительской работы и повышения информированности населения в отношении мер индивидуальной и коллективной защиты от комаров, клещей, клопов, мух и других переносчиков инфекций.
Важнейшим фактором в борьбе с болезнями и их ликвидацией является доступ к воде и средствам санитарии. ВОЗ проводит совместную работу со многими государственными секторами, направленную на совершенствование систем аккумулирования воды и водоотведения, тем самым содействуя осуществлению контроля за заболеваниями на уровне общин.
13.07.2020 Паразитарные заболевания: как распознать и предупредить
Паразитарные заболевания по распространённости уступают лишь респираторным инфекциям, утверждают специалисты. И актуальны они в любое время года. По данным учёных, паразиты, грибки и патогенные бактерии отравляют организм каждого третьего человека в мире, провоцируют заболевания желудочно-кишечного тракта и многие другие нарушения здоровья. По статистическим данным, ежегодно в мире свыше пяти миллиардов людей страдают паразитарными болезнями. Наблюдается тенденция к увеличению этой цифры. Любопытно то, что в начале XXI века учёные выяснили, что 95% населения Земли заражено паразитами, а 99,9% людей, у которых есть домашние животные, включая грызунов и птиц, являются носителями паразитов. В России ежегодно регистрируется до 1,5 миллионов случаев этих заболеваний.
«Паразитарные заболевания — группа болезней, вызываемых паразитами, патогенными бактериями и грибками. Паразиты живут за счёт другого организма, питаются его энергией и клетками. Они поглощают витамины и все полезные вещества. Кроме того, они отравляют организм продуктами своей жизнедеятельности», - говорит помощник врача-эпидемиолога ТОГБУЗ «ГКБ №3 г.Тамбова» Е.В. Моисеева. Далее специалист рассказала о причинах паразитарных заболеваний и о мерах профилактики.
ПРИЧИНЫ
Причинами появления паразитов в организме могут стать: сырые фрукты и овощи; фастфуд; термически плохо обработанная пища или еда, включающая в себя сырые продукты: суши, роллы; недостаточно прожаренное мясо. Не стоит также забывать о домашних питомцах — они являются одним из основных источников распространения паразитов, патогенных бактерий и грибков.
Паразиты проникают в организм через рот, кожу и слизистые оболочки. И при соответствующих условиях тут же начинают развиваться. Паразиты могут вызывать аллергизацию организма, а также понижают его сопротивляемость инфекциям, создают предрасположенность к хроническим заболеваниям. При длительном существовании паразитов в организме человека страдают не только органы, но и иммунная система в целом. В таких случаях развиваются тяжёлые хронические заболевания.
ПРИЗНАКИ ПАРАЗИТАРНЫХ ЗАБОЛЕВАНИЙ
Первичные симптомы паразитарных заболеваний нередко маскируются под признаки следующих наиболее распространённых болезней.
Иммунные нарушения.
При этом появляются признаки хронической усталости, апатия, депрессия, потеря концентрации и плохая память. Недостаток питательных веществ в организме создаётся из-за плохого всасывания белков, жиров, углеводов и особенно витаминов А и В12.
Аллергические реакции.
Паразиты могут вызывать нарушения функций желудочно-кишечного тракта, что является причиной аллергических реакций.
Проблемы с кожей.
Кишечные паразиты могут вызывать крапивницу, сыпь, экзему и другие кожные реакции.
Скрежет зубов во сне.
Бруксизм — сжатие зубов и трение ими часто сопровождает многие паразитические инфекции.
Боли в суставах и мышцах.
Боли и воспаления суставов и мышц являются результатом травмирования тканей некоторыми паразитами либо иммунной реакцией на их присутствие.
Нарушение сна.
Частые пробуждения среди ночи могут быть попыткой организма избавиться от токсических веществ через печень.
Анемия.
Некоторые виды кишечных паразитов присасываются к оболочке кишок и высасывают питательные вещества у хозяина. Находясь в организме в большом количестве, они могут вызывать достаточно большую потерю крови, что приводит к потере железа организмом.
ЗАБОЛЕВАНМЯ, ВЫЗЫВАЕМЫЕ ПАРАЗИТАМИ
Некоторые специалисты утверждают, что паразиты являются главной причиной ожирения, поскольку лишают организм необходимых питательных веществ. Организм начинает требовать все больше пищи, поскольку ему не хватает витаминов и минералов, и человек прибавляет в весе.
Наличие паразитов, патогенных бактерий и грибков в организме может привести к развитию серьёзных заболеваний. Подавление нормальной микрофлоры грибками способствует развитию дисбактериоза, а изменение кислой среды в толстом кишечнике провоцирует возникновение патогенной микрофлоры, которая и приводит к развитию заболеваний.
Паразиты могут внедряться в стенки кровеносных сосудов и разрушать их, тем самым провоцируя инфаркт миокарда и ряд других серьёзных заболеваний: воспаление половых органов, поджелудочной железы, печени.
СЕМЬ ОСНОВНЫХ ПРАВИЛ ПРОФИЛАКТИКИ
Правило №1.
Тщательнее и чаще мойте руки. Большинство паразитарных заболеваний возникает из-за пренебрежения правилами гигиены.
Правило №2.
Тщательно мойте овощи, фрукты, ягоды и зелень.
Правило №3.
Не грызите ногти, карандаши и другие предметы.
Правило №4.
Тщательно прожаривайте рыбу и мясо.
Правило №5.
Пейте только фильтрованную воду.
Правило №6.
Ограничивайте контакты с домашними животными. Не разрешайте им лизать лицо, прыгать на диван или кровать.
Правило №7.
По возможности очистите свой дом от старых, запылившихся ковров — они также являются источником паразитов.
Десять простейших паразитов человека
В человеческом организме живет множество простейших. Многие из них патогенны. Наш рассказ о десяти из них, самых-самых. Обзор составлен как по историческим, так и по самым свежим публикациям.

Наталья Резник
Самый большой. Балантидий Balantidium coli

Крупнейшее простейшее — паразит человека, и единственная инфузория в этой компании. Ее размеры варьируют от 30 до 150 мкм в длину и от 25 до 120 мкм в ширину. Для сравнения: длина малярийного плазмодия в самой крупной стадии — около 15 мкм, и в разы меньше балантидия клетки кишечника, среди которых живет инфузория. Слон в посудной лавке.
Распространен везде, где есть свиньи — его основные носители. Обычно живет в подслизистом слое толстой кишки, хотя у людей встречается и в легочном эпителии. Питается B. coli бактериями, частичками пищи, фрагментами хозяйского эпителия. У животных инфекция протекает бессимптомно. У людей может развиться тяжелейшая диарея с кровавыми, слизистыми выделениями (балантидиаз), иногда в стенках толстой кишки образуются язвы. Умирают от балантидиаза редко, однако он вызывает хроническое истощение.
Люди заражаются через грязную воду или продукты, содержащие цисты. Частота инфицирования у людей не превышает 1%, в то время как свиньи могут быть заражены поголовно.
Открыт шведским ученым Мальстемом в 1857 году. Сегодня балантидиаз связывают с тропическими и субтропическими районами, бедностью и плохой гигиеной.
Самая первая. Ротовая амеба Entamoeba gingivalis

Первая паразитическая амеба, найденная у человека. Этот человек был москвичом, и описание его амеб опубликовал московский исследователь Г. Гросс в 1849 году в Bulletin de la Société Impériale des Naturalistes de Moscou — старейшем русском научном журнале (выходит с 1829 года и посейчас индексируется ВАК под именем «Бюллетень Московского общества испытателей природы»). Гросс обнаружил амебу в зубном налете, отсюда и название от латинского gingivae — десны.
Живет во рту почти у всех людей с больными зубами или воспаленными деснами, населяет десневые карманы и зубной налет. Питается клетками эпителия, лейкоцитами, микробами, при случае эритроцитами. У людей со здоровой ротовой полостью встречается редко.
Это небольшое простейшее размером 10–35 мкм во внешнюю среду не выходит и цист не образует, к другому хозяину передается при поцелуях, через грязную посуду или зараженную пищу. E. gingivalis считают исключительно человеческим паразитом, но иногда ее находят у кошек, собак, лошадей и обезьян, живущих в неволе.
В начале ХХ века E. gingivalis описали как возбудителя пародонта, поскольку она всегда присутствует в воспаленных зубных ячейках. Однако ее патогенность не доказана.
Лекарства, действующие на эту амебу, неизвестны.
Самый всепроникающий. Дизентерийная амеба Entamoeba histolytica

Этот кишечный паразит с кровью проникает в ткани печени, легких, почек, мозга, сердца, селезенки, половых органов. Ест, что добудет: частички пищи, бактерии, эритроциты, лейкоциты и клетки эпителия.
Распространена повсеместно, особенно в тропиках. Обычно люди заражаются, проглотив цисту.
В странах умеренного климата амеба, как правило, остается в просвете кишечника, и инфекция протекает бессимптомно. В тропиках и субтропиках чаще начинается патологический процесс: E. histolytica атакуют стенки. Причины перехода в патогенную форму пока неясны, но описано уже несколько молекулярных механизмов происходящего. Так, понятно, что амебы выделяют лизирующие вещества, пробиваются через слизь и убивают клетки. По-видимому, амеба может уничтожить хозяйскую клетку двумя способами: запустив у нее апоптоз или просто отгрызая куски. Первый способ долгое время считался единственным. Кстати, механизм клеточного самоубийства с рекордной скоростью — за минуты — так и не выявлен. Второй способ описан совсем недавно, авторы назвали его трогоцитозом от греческого «трого» — грызть. Примечательно, что амебы, кусающие клетки, бросают добычу, как только она погибает. А другие могут фагоцитировать мертвые клетки целиком. Предполагают, что кусающие и пожирающие клетки различаются картиной экспрессии генов.
Сейчас способность амебы проникать в кровяное русло, печень и другие органы связывают именно с трогоцитозом.
Амебиаз — смертельно опасное заболевание, ежегодно от инфекции E. histolytica умирает около 100 тыс. человек.
У дизентерийной амебы есть непатогенный близнец, E. dispar, поэтому для диагностики заболевания микроскопии недостаточно.
Для излечения необходимо уничтожить как подвижных E. histolytica (метронидазол, тинидазол), так и цисты (иодокинол или паромомицин).
Описал E. histolytica в 1875 году петербургский врач Федор Александрович Лёш у больного диареей, он же определил ее патогенную природу. Но латинское название амебе дал в 1903 году немецкий зоолог Фриц Шаудин. Histolytica означает «разрушающая ткани». В 1906 году ученый умер именно от амебного абсцесса кишечника.
Самый распространенный. Кишечная лямблия Giardia lamblia (G.intestinalis)

Лямблия, самый распространенный паразит кишечника, встречается повсеместно. Заражены 3–7% людей в развитых странах и 20–30% в развивающихся. То есть примерно 300 млн. человек.
Обитают паразиты в двенадцатиперстной кишке и желчных протоках хозяина, где то плавают, работая жгутиками, то прикрепляются к эпителию с помощью клейкого диска, расположенного на нижней стороне клетки. На 1 см 2 эпителия налипает до миллиона лямблий. Они повреждают ворсинки, что нарушает всасывание питательных веществ, вызывает воспаление слизистой оболочки и диарею. Если болезнь затрагивает желчные протоки, она сопровождается желтухой.
Лямблиоз — болезнь грязных рук, воды и продуктов. Жизненный цикл простейшего прост: в кишечнике — активная форма, а на выходе с фекальными массами — устойчивые цисты. Чтобы заразиться, достаточно проглотить десяток цист, которые в кишечнике опять перейдут в активную форму.
Главный секрет повсеместности лямблий в изменчивости поверхностных белков. Организм человека борется с лямблиями антителами и, в принципе, способен выработать иммунитет. Но люди, живущие в одной и той же местности и пьющие одну и ту же воду, заражаются снова и снова потомками своих же паразитов. Почему? Потому что при переходе от активной фазы к цисте и обратно лямблия изменяет белки, к которым вырабатываются антитела, — вариант-специфичные поверхностные белки (variant-specific surface protein). В геноме есть около 190 вариантов этих белков, но на поверхности отдельного паразита всегда присутствует лишь один, трансляция остальных прерывается по механизму РНК-интерференции. А смена случается примерно раз на десять поколений.
Лечится метронидазолом. Болезнь проходит за неделю, но при инфицировании желчных протоков рецидивы возможны в течение многих лет. С цистами борются, иодируя воду.
Открыл Giardia lamblia в 1859 году чешский ученый Вилем Ламбль. С тех пор простейшее сменило несколько названий и нынешнее получило в честь первооткрывателя и французского паразитолога Альфреда Жиара, который лямблию не описывал.
А первую зарисовку лямблии сделал Антони ван Левенгук, обнаружив ее в собственном расстроенном стуле. Было это в 1681 году.
Кстати, лямблия еще и очень эволюционно древняя, происходит чуть ли не прямо от предка всех эукариот.
Самый интимный. Влагалищная трихомонада Trichomonas vaginalis.

Простейшее, которое передается половым путем. Обитает во влагалище, а у мужчин — в мочеиспускательном канале, эпидидимисе и предстательной железе, передается половым путем или через влажные мочалки. Младенцы могут заразиться, проходя через родовые пути. У T. vaginalis 4 жгутика на переднем конце и относительно короткая ундулирующая мембрана, при необходимости он выпускает ложноножки. Максимальные размеры трихомонады — 32 на 12 мкм.
Трихомонада более распространена, чем возбудители хламидиоза, гонореи и сифилиса вместе взятые. Ей поражено около 10% женщин, а возможно и больше, и 1% мужчин. Последняя цифра недостоверна, потому что у мужчин сложнее обнаружить паразита.
T. vaginalis питается микроорганизмами, в том числе молочнокислыми бактериями вагинальной микрофлоры, которые поддерживают кислую среду, и таким образом создает оптимальный для себя рН выше 4.9.
Трихомонада разрушает клетки слизистой оболочки, вызывая воспаление. На симптомы жалуются около 15% инфицированных женщин.
Лечится метронидазолом, но беременным он противопоказан. В качестве профилактики рекомендуют регулярные спринцевания разбавленным уксусом.
Описан в 1836 году французским бактериологом Альфредом Донне. Ученый не понял, что перед ним патогенный паразит, но определил размеры, внешность и тип движения простейшего.
Самый убийственный. Возбудитель сонной болезни Trypanosoma brucei

Возбудитель африканской сонной болезни — самое убийственное простейшее. Зараженный им человек без лечения умирает. Трипаносома — вытянутый жгутиконосец длиной 15—40 мкм. Известны два подвида, внешне неотличимые. Заболевание, вызванное T. brucei gambiense, длится 2—4 года. T. brucei rhodesiense — более вирулентный, возбудитель скоротечной формы, от которой умирают через несколько месяцев или недель.
Распространен в Африке, между 15-ми параллелями Южного и Северного полушарий, в естественном ареале переносчика — кровососущих насекомых рода Glossina (муха цеце). Из 31 вида мух для человека опасны 11. От сонной болезни страдает население 37 стран к югу от Сахары на 9 млн. км 2 . Ежегодно заболевает до 20 тыс. человек. Сейчас больных около 500 тыс., 60 млн. живут в зоне риска.
Из кишечника мухи T. brucei попадает в кровь человека, оттуда проникает в спинномозговую жидкость и поражает нервную систему. Болезнь начинается с лихорадки и воспаления лимфатических желез, затем следуют апатия, сонливость, мышечный паралич, истощение и необратимая кома.
Смертельность паразита связывают с его способностью преодолевать гематоэнцефалический барьер. Молекулярные механизмы до конца не изучены, но известно, что при проникновении в мозг паразит выделяет цистеиновые протеазы, а также использует некоторые белки хозяина. В центральной нервной системе, с другой стороны, трипаносома укрывается от иммунных факторов.
Первое описание сонной болезни в верховьях Нигера оставил арабский ученый ибн Хальдун (1332—1406). В начале XIX века европейцам был уже хорошо знаком начальный признак заболевания — вздутие лимфатических узлов на задней стороне шеи (симптом Уинтерботтома), и работорговцы обращали на него особое внимание.
Открыл T. brucei шотландский микробиолог Дэвид Брюс, в честь которого она и названа, а в 1903 году он впервые установил связь между трипаносомой, мухой цеце и сонной болезнью.
Лечение зависит от стадии заболевания, лекарства вызывают тяжелые побочные эффекты. Паразит обладает высокой антигенной изменчивостью, поэтому вакцину создать невозможно.
Самый экстравагантный. Лейшмания Leishmania donovani

Лейшмании заслужили звание самых экстравагантных паразитов, потому что живут и размножаются в макрофагах — клетках, призванных паразитов уничтожать. L. donovani — самая опасная из них. Она вызывает висцеральный лейшманиоз, в просторечье лихорадку думдум, или кала-азар, от которой без лечения умирают почти все заболевшие. Зато выжившие приобретают длительный иммунитет.
Существует три подвида паразита. L. donovani infantum (Средиземноморье и Средняя Азия) поражает в основном детей, его резервуаром часто служат собаки. L. donovani donovani (Индия и Бангладеш) опасен для взрослых и пожилых людей, природных резервуаров не имеет. Американский L. donovani chagasi (Центральная и Южная Америка) может жить в крови собак.
L. donovani — жгутиконосец не более 6 мкм в длину. Люди заражаются после укуса москитов рода Phlebotomus, иногда при половом контакте, младенцы — проходя через родовые пути. Попав в кровь, L. donovani проникают внутрь макрофагов, которые разносят паразита по внутренним органам. Размножаясь в макрофагах, паразит их разрушает. Молекулярный механизм выживания в макрофагах довольно сложен.
Симптомы заболевания — лихорадка, увеличение печени и селезенки, анемия и лейкопения, которые способствуют вторичной бактериальной инфекции. Ежегодно висцеральным лейшманиозом заболевает 500 тыс. человек и около 40 тыс. умирает.
Лечение тяжелое — внутривенное введение препаратов сурьмы и переливание крови.
Таксономическую принадлежность L. donovani определил в 1903 году знаменитый исследователь малярии и нобелевский лауреат Рональд Росс. Родовым названием она обязана Уильяму Лейшману, а видовым — Чарльзу Доновану, которые в том же 1903 году независимо обнаружили клетки простейших в селезенке больных, умерших от кала-азара, один — в Лондоне, другой — в Мадрасе.
Самый сложный жизненный цикл. Babesia spp.
Бабезии, помимо многоступенчатого бесполого размножения в эритроцитах млекопитающего и полового в кишечнике клещей рода Ixodes, осложнили свое развитие трансовариальной передачей. Из кишечника самки клеща спорозоиты простейшего проникают в яичники и заражают эмбрионы. Когда личинки клещей вылупляются, бабезии переходят в их слюнные железы и с первым укусом входят в кровь позвоночного.
Распространены бабезии в Америке, Европе и Азии. Их природный резервуар — грызуны, собаки и крупный рогатый скот. Человека заражают несколько видов: B. microti, B. divergens, B. duncani и B. venatorum.
Симптомы бабезиоза напоминают малярию — периодическая лихорадка, гемолитическая анемия, увеличенные селезенка и печень. Большинство людей выздоравливает спонтанно, для больных с ослабленной иммунной системой бабезиозы фатальны.
Методы лечения еще разрабатывают, пока что прописывают курс клиндамицина с хинином, а в тяжелых случаях — переливание крови.
Описал бабезию румынский микробиолог Виктор Бабеш (1888), обнаруживший ее у больных коров и овец. Он решил, что имеет дело с патогенной бактерией, которую назвал Haematococcus bovis. Бабезию долго считали патогеном животных, пока не обнаружили ее в 1957 году у югославского пастуха, умершего от заражения B. divergens.
Самый влиятельный. Возбудитель токсоплазмоза Toxoplasma gondii

T. gondii — самый влиятельный паразит, поскольку управляет поведением промежуточных хозяев.
Распространен повсеместно, распределен неравномерно. Во Франции, например, заражено 84% жителей, в Соединенном Королевстве —22%.
Жизненный цикл токсоплазмы состоит из двух стадий: бесполая протекает в организме любых теплокровных, половое размножение возможно только в эпителиальных клетках кошачьего кишечника. Чтобы T. gondii могла завершить развитие, кошка должна съесть зараженного грызуна. Повышая вероятность этого события, T. gondii блокирует естественный страх грызунов перед запахом кошачьей мочи и делает его привлекательным, воздействуя на группу нейронов в миндалине. Как она это делает — неизвестно. Один из предполагаемых механизмов воздействия — локальный иммунный ответ на инфекцию. Он изменяет содержание цитокинов, что, в свою очередь, повышает уровень нейромодуляторов, таких как дофамин. Влияет токсоплазма и на поведение людей, что проявляется даже на популяционном уровне. Так, в странах с высоким уровнем токсоплазмоза чаще встречается невротизм и желание избегать неопределенных, новых ситуаций. Возможно, инфицированность T. gondii может привести к культурным изменениям.
Инфекция у человека чаще протекает бессимптомно, но при ослабленном иммунитете разрушает клетки печени, легких, мозга, сетчатки, вызывая острый или хронический токсоплазмоз. Течение инфекции зависит от вирулентности штамма, состояния иммунной системы хозяина и его возраста — пожилые люди менее восприимчивы к T. gondii.
Лечат токсоплазмоз пириметамином и сульфадиазином.
Описан в 1908 году у пустынных грызунов. Эта честь принадлежит сотрудникам Института Пастера в Тунисе Шарлю Николю и Луису Мансо.
Самый патогенный. Малярийный плазмодий Plasmodium spр.
Малярийный плазмодий — самый патогенный паразит человека. Число больных малярией может достигать 300–500 млн., а смертность во время эпидемий — 2 млн. Болезнь до сих пор уносит в три раза больше жизней, чем вооруженные конфликты.
Малярию у человека вызывают пять видов плазмодия: Plasmodium vivax, P. falciparum, P. malariae, P. ovale и P. knowlesi, который поражает также макак.
Распространен в ареале переносчиков — комаров Anopheles, которым нужна температура 16–34°С и относительная влажность более 60%.
Сравнение генома самого вирулентного из плазмодиев, P. falciparum, с плазмодиями горилл, позволяет предполагать, что его предком люди заразились именно от этих обезьян. Возникновение этой формы плазмодия связывают с появлением сельского хозяйства в Африке, повлекшего за собой увеличение плотности населения и развитие оросительных систем.
Половое размножение плазмодиев происходит в кишечнике комаров, а в организме человека это внутриклеточный паразит, который живет и размножается в гепатоцитах и эритроцитах до тех пор, пока клетки не лопаются. В 1 мл крови больного содержится 1 — 50 тыс. паразитов.
Болезнь проявляется как воспаление, периодическая лихорадка и анемия, в случае беременности опасна для матери и плода. Эритроциты, зараженные P. falciparum, закупоривают капилляры, и в тяжелых случаях развивается ишемия внутренних органов и тканей.
Лечение требует комбинации нескольких препаратов и зависит от конкретного возбудителя. Плазмодии приобретают устойчивость к лекарствам.
Читайте также:
